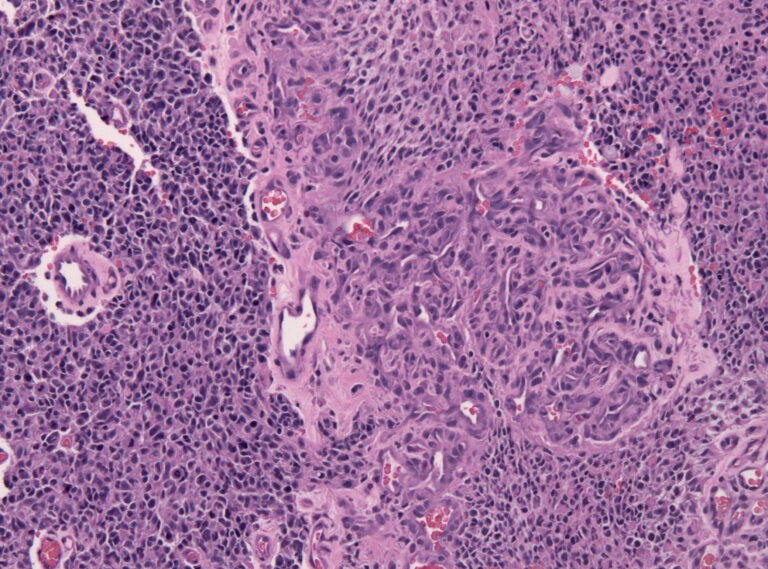

Penn researchers believe new potential gene therapy for glioblastoma brain cancer offers ‘a lot of hope’
Glioblastoma has been deadly and hard to treat, but researchers say they’ve made progress with bivalent CAR T-cell therapy delivered directly into the brain.
Listen 1:21
Biopsy specimen of a glioblastoma with prominent micovascular proliferation (formation of a mulitlayered "glomeruloid tuft", HE stain). (Jensflorian, CC BY-SA 3.0
From Philly and the Pa. suburbs to South Jersey and Delaware, what would you like WHYY News to cover? Let us know!
Researchers at the University of Pennsylvania believe they’re one step closer to finding a treatment that fights glioblastoma, the deadliest form of brain cancer.
Public figures who’ve died from the disease include Beau Biden, John McCain, Mia Love and most recently, Uche Ojeh — husband of “Today” show co-host and Philadelphia native, Sheinelle Jones.
The new treatment uses CAR T-cell therapy, which is a process that takes patients’ own T cells from their immune system and modifies them to identify specific cancer cell antigens, or markers.
The engineered T cells then get injected back into the patient where they seek out these markers on the surface of cancer cells and tumors to fight and destroy them.
While CAR T has been highly successful in treating and even curing blood cancers like leukemia and lymphoma, neurosurgeon Dr. Donald O’Rourke said the therapy hasn’t been as effective in fighting solid tumors like glioblastoma. But he hopes that will now change.
“We think it’s a pathway to a new approach to get long-term remission, and then ultimately a cure,” he said. “We’re not there yet, but we think we’re getting such encouraging results.”
Changes to CAR T delivery and cell targets
Researchers and scientists have made two major changes to their CAR T-cell therapy for glioblastoma. First, it is delivered directly into the brain through a device that is implanted in the scalp, rather than injected into the spine and spinal fluid.
Second, they made the treatment bivalent, meaning it targets not just one glioblastoma cell marker, but two.
“If you’re just targeting one, you’re not getting enough coverage of the tumor,” O’Rourke said.
The research team tested the therapy in a small group of 18 patients with recurrent glioblastoma in a phase 1 clinical trial, which primarily examines the treatment’s safety profile.
The most common side effect was neurotoxicity, or damage to the brain or nervous system, but it was reversible within several days for nearly all patients, according to new study results published June 1 in Nature Medicine.
Data showed that most clinical trial patients saw their tumors shrink to some degree, which O’Rourke said could buy people more time in remission.
“We’re not looking for a small couple months here. We’re talking about something that could be a major hit. We have one guy out over 20 months now with a four-week life expectancy before he was treated and he’s free of disease at 20 months,” he said. “So, I think there’s a lot of hope in this.”
A pathway to a future cure
O’Rourke, who has studied and researched treatments for glioblastoma for more than 25 years, called the treatment and its early outcomes the “most potent, and this is the most powerful and the most promising by far.”
Currently, the average life expectancy for someone diagnosed with the aggressive form of brain cancer is 12 to 18 months, and shorter at three to nine months for people with recurrent glioblastoma.
Glioblastoma is especially tricky, O’Rourke said, because it presents differently in all patients. It also mutates and becomes resistant to treatments like chemotherapy and radiation, so most patients experience recurrence, or tumor regrowth, after a period of remission.
With the new approach to CAR T-cell therapy, a new option has emerged, and he sees opportunities to make this treatment even stronger.
“There are some modifications that we can make that might get us more anti-tumor response or more durable anti-tumor responses,” O’Rourke said. “I wouldn’t oversell it as a cure, but it is on the pathway to, I’d say, a new category of drugs that could give us much longer-term remissions in glioblastoma.”
The therapy is still in an early phase 1 clinical trial. Penn experts hope to test the CAR T-cell therapy among patients who are newly diagnosed with glioblastoma, because their tumors may have fewer resistance factors that can develop from previous treatment.
Eventually, researchers plan to scale up drug manufacturing in order to do large efficacy studies involving more patients and clinical sites with the ultimate goal of obtaining federal drug approval.

Get daily updates from WHYY News!
WHYY is your source for fact-based, in-depth journalism and information. As a nonprofit organization, we rely on financial support from readers like you. Please give today.